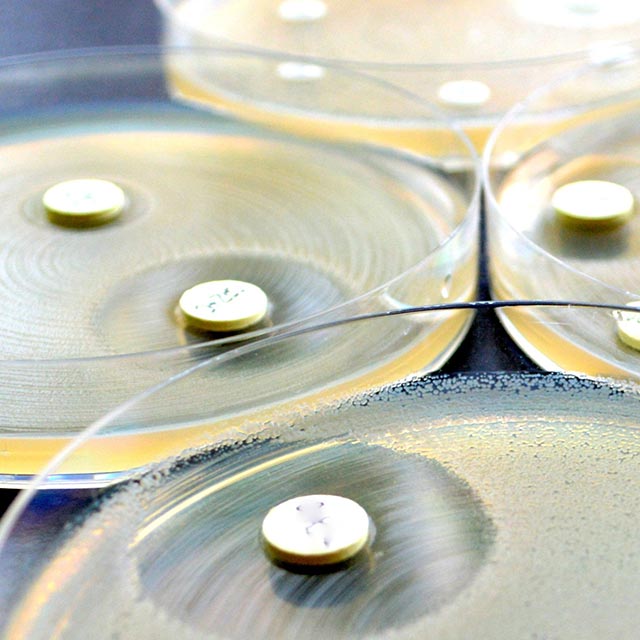

Harnessing the power of the sun using microalgae systems
By 2050 the human population is forecast to expand from 7.5 to 9.6 billion people. We will require 70% more food (United Nations), 50% more fuel (International Energy Agency), and 50% more water (Organization for Economic Co-operation and Development). We also need to reduce CO2 emissions by over 80% (Intergovernmental Panel on Climate Change). All of these will have to be achieved to ensure economic, social, political, climate, food, water and fuel security.
The Centre for Solar Biotechnology connects around 30 international research teams and its industry partners to accelerate the innovation and commercialisation of new solar powered technologies and industries, based on photosynthetic green algae. Our green-algae technologies tap into the huge energy resource of the sun and absorb CO2 to provide economic solar driven solutions that will help supply the world’s growing energy, food and water needs, and a path for CO2 utilisation. Our technologies also open up a suite of high-value opportunities in the nutraceutical and pharmaceutical sectors.
Collectively, our work actively supports the development of new job opportunities, sustainable regional development, export industries and a clean, green and renewable future.
Read more on Nature.com.
Contact
Professor Ben Hankamer
P: +61 7 3346 2012
E: b.hankamer@imb.uq.edu.au
- Facilitating the integration of aesthetic, architectural microalgae production units into rapidly evolving roadscapes.
- Delivering enhanced human nutrition options in the food and health industries.
- Developing advanced microalgae systems that use solar energy and CO2 to produce crude oil, biodiesel, jet fuel, ethanol, methane and hydrogen.
- Using microalgae to produce high-value designer proteins, such as protein therapeutics, vaccines, antibody therapies, industrial enzymes and novel biomaterials.
- Creating robust and economic greenhouse systems—that can be integrated with existing field production—to enhance productivity, resilience, resource efficiency and sustainability.
- Integrating modular microalgae systems into buildings and urban infrastructure to create eco-cityscapes.
- Integrating microalgae technologies into innovative and sustainable land management practices, to improve water quality, soil biology, crop health and fertiliser efficiency.
- Delivering innovative microalgae functional feeds to better meet the increasing needs of the aquaculture and livestock industries.
-
Bioinspired design of solar biotechnology systems
Hankamer Group -
Molecular biodiscovery: learning from nature
Capon Group -
Bugs and drugs
King Group
The advanced pilot-scale test facility, located at Pinjarra Hills, Brisbane, develops high-efficiency microalgae systems and processes for the production of high value products as well as bulk commodities.
These include foods, renewable fuels, advanced bioproducts and bioremediation.
Further capabilities within the facility include the following:
Strain purification
Advanced microalgae purification strategies that have undergone extensive development and testing and can be configured to the recovery of species from a wide range of water sources. Strain purification is now available as a service.
Cryopreservation
Advanced microalgae cryopreservation techniques have been developed and tested. Strain cryo-preservation is available as a service.
Nutrient optimisation
Advanced high throughput nutrient optimisation screening that identifies the best nutrient blends based on the analysis of over 200 different combinations has been developed and tested and is now available as a service.
Light optimisation
Light capture is the first stage of all biofuel and bio-products production. The optimisation of light delivery and light capture are therefore essential to the development of high-efficiency processes. Screens can now be provided to assist with the optimisation of light capture and can be tailored to specific needs. Our engineering partners can assist with engineering aspects of bioreactor design.
Metabolomics and metabolic engineering
For efficient product production it is important to channel the captured solar energy into downstream products such as oils, carbohydrates, proteins or specific High Value Products. Our team has substantial skills and facilities for the analysis of metabolites and targeted metabolic engineering.
High-value product development and screening
We encourage external groups to use our equipment. We offer training and induction. We also have highly trained staff that can perform the imaging for you.
Extensive facilities are available for the screening and purification of high value products.
Photobioreactor and raceway system design
Our team has extensive experience in photobioreactor design and process engineering.
Technoeconomic analysis
Our team has extensive experience in economic modelling of microalgae production. Economic modelling can be provided as a service.
Scale-up
This facility provides a research hub to facilitate collaborative and contract research projects based on photo-bioreactors and raceway systems. Services can be provided in systems design and testing.
This pilot-scale test facility is currently being upgraded to include additional capabilities, such as:
- improved containment and safety
- enhanced systems
- extensive equipment upgrades
- new sterilisation facilities
- PC2 laboratories.
For further information please contact Dr Evan Stephens e.stephens@imb.uq.edu.au
Partnering enquiring minds with state-of-the-art technologies to create solutions to health and environmental problems
Earth's Solar Interface by Rohan Drysdale
UQ Global Leadership Series: Welcome to our biofuture, May 2017, featuring Professor Ben Hankamer and Professor Karen Hussey
Launch of the IMB algal biofuels pilot plant, June 2013
UQ ChangeMakers magazine feature on Prof Ben Hankamer's research, Jan 2017